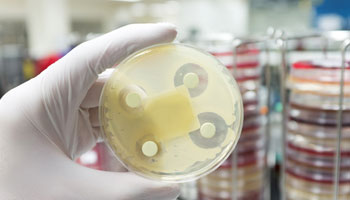
Collaborating to combat superbugs: the GRDI AMR-One Health Project

Learn from scientists, researchers, technicians and veterinarians about their work. Find out about their research, collaborations and innovative science activities designed to safeguard food, animals and plants, and enhance the well-being of Canada's people, environment and economy.
Collaborating to combat superbugs: the GRDI AMR-One Health Project
February 2026 | Canadian Food Inspection Agency | by the GRDI AMR-OH project team
Is playing a game of “Spot the Difference” the key to outsmarting weeds?
January 2026 | Canadian Food Inspection Agency | by Saanchi Singh
Traps, trees, and teamwork: How plant health surveillance protects Canada’s green spaces
September 2025 | Canadian Food Inspection Agency
Early detection for rapid protection – monitoring milk for avian influenza
September 2025 | Canadian Food Inspection Agency | by Cathy Furness and Rod Lister
Healthy vines make Canadian wines
August 2025 | Canadian Food Inspection Agency | by Mike Rathjen
One-on-one with Julie Holmes: Protecting plant health from the ground up
May 2025 | Canadian Food Inspection Agency | by Julie Holmes, Plant Health Survey Biologist
February 2025 | Agriculture and Agri-Food Canada
Protecting Canadians from the leading cause of Salmonella illnesses in Canada
February 2025 | Canadian Food Inspection Agency | by Kelvin Chau and Bethany Staye
Older Cultivating Science blog posts